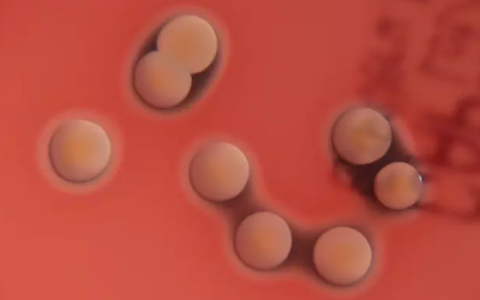
10岁男孩海边磕破脚后跟险些丧命：血压下降出现休克征兆

互联网
-
10岁男孩海边磕破脚后跟险些丧命:血压下降出现休克征兆
快科技7月3日消息,据媒体报道,厦门10岁男孩浩浩(化名)在海边散步时,不慎在礁石上磕破了右脚后跟。疼痛轻微,未见明显出血,孩子和家长都未在意。 然而,几天后,浩浩右大腿根部突然出…
-
电动时代 Stellantis却复活了SRT和HEMI V8
快科技7月3日消息,如今,发展新能源汽车已经成为各大车企的首要目标,但是,有一家企业却背道而驰,决定重新启用大排量发动机以及高性能品牌。 Stellantis集团宣布将复活SRT子…
-
男子用无人机直播看守所被抓:起初我不敢飞 粉丝说别怕 我就飞了
快科技7月3日消息 ,近期,公安查处了一起无人机“黑飞”案件。一男子“黑飞”无人机进行直播被抓。 据了解,案发时,男子为满足粉丝要求,竟将无人机飞到看守所上空(禁飞区域)近距离直播…
-
弃自研转外购!英特尔计划叫停玻璃基板开发:直接采用外部现成方案
快科技7月3日消息,据媒体报道,随着新任首席执行官陈立武(Lip-Bu Tan)启动一系列改革措施,英特尔正在对旗下业务及开发工作进行调整。 据悉,这家芯片巨头或将放弃自主开发的玻…
-
珠峰每年向东北长春移动4.2厘米:我国国土越来越小了!
快科技7月3日消息,地理知识告诉我们,地球板块一直都在移动,重塑地形,比如珠穆朗玛峰和整个青藏高原,就是印度板块和亚欧板块碰撞挤压而成的,而且依然是板块运动最活跃的地方,珠峰其实一…
-
你怎么看!日本将征收单身税被挤上热搜:每人每个月最高需缴纳85元
7月3日消息,据国外媒体报道称,日本政府计划自2026年4月起实施“儿童与育儿支援金”制度,意在鼓励年轻人结婚、生育,以缓解人口下降危机。 由于涉及向未育或未婚群体征收资金,该政策…
-
别看笑话了!小米玄戒O1在中国市场开了个好头:上来就快干掉三星
快科技7月3日消息,对于雷军来说,玄戒O1技术验证成功后,接下来小米的自研芯片在量能上必然会井喷。 从最新统计的2025年第二季度的用户偏好数据看,在最新安卓阵营处理器品牌分布情况…
-
腾讯揭秘鸿蒙微信开发:必须从零重写 终极目标超越iOS
快科技7月3日消息,微信鸿蒙版自从正式上线以来,一直保持高速迭代状态,持续不断加入了很多功能,目前基础体验相较之前已经完善许多。 昨天,微信还上线了全新一版,带来了拍一拍文案、扫一…
-
雷军:如果大家着急用车 可以考虑一下小鹏、理想和Model Y
快科技7月3日消息,在昨晚直播中,雷军表示:“如果大家着急用车,可以考虑一下小鹏G7、理想i8,甚至可以考虑下Model Y,因为我看到特斯拉近期出了很多优惠政策。” 对此,不少网…
-
全球EDA巨头将恢复供应 新思科技称美国撤销对华出口限制
快科技7月3日消息,今日,据第一财经报道,新思科技表示,7月2日收到美国商务部工业和安全局(BIS)的通知,称与中国相关的出口限制现已撤销,立即生效。 新思科技正努力恢复在中国销售…